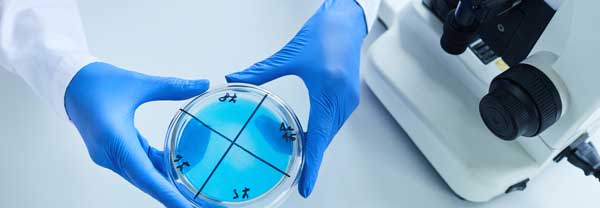

10
Standorte
6
Spezialisten
2k
Zufriedene Patienten
#1
Auf unserem Gebiet
Ihre Gesundheit liegt uns am Herzen - deshalb sind wir hier.
Lorem ipsum dolor sit amet, consetetur sadipscing elitr, sed diam nonumy eirmod tempor invidunt ut labore et dolore magna. Lorem ipsum dolor sit amet, consetetur sadipscing elitr, sed diam nonumy eirmod tempor invidunt ut labore et dolore magna.
Lorem ipsum dolor sit amet, consetetur sadipscing elitr, sed diam nonumy eirmod tempor invidunt ut labore et dolore magna.